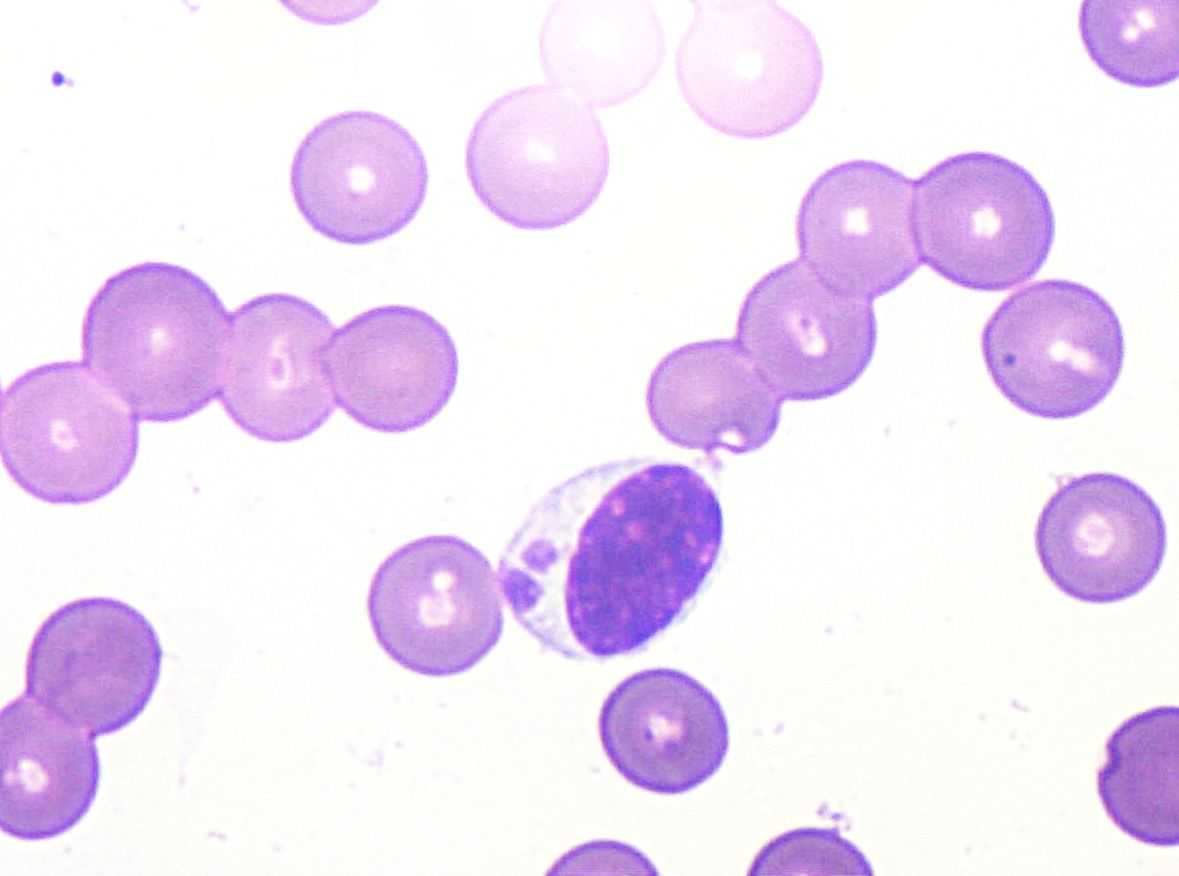
Hematologia

Falasca vet
Laboratório de Análises Clínicas.


A clínica veterinária Falasca Vet oferece serviços de qualidade em Marília, SP. Confie na nossa expertise!
A Falasca vet oferece serviços veterinários de alta qualidade em Marília, SP. Entre em contato conosco pelo WhatsApp para agendar uma consulta.
Nossos Serviços
Conheça nossos serviços de Laboratório e Atendimento Domiciliar em Marília, SP. Acesse os componentes abaixo para mais informações.

Fale Conosco
Clique no botão e converse com a gente no WhatsApp
Horários de atendimento:
Segunda: das 09:00 às 18:30
Terça: das 09:00 às 18:30
Quarta: das 09:00 às 18:30
Quinta: das 09:00 às 18:30
Sexta: das 09:00 às 18:30
Sábado: das 09:00 às 13:00
Domingo: Fechado
Telefones para contato:
WhatsApp:(14) 99140 - 5391